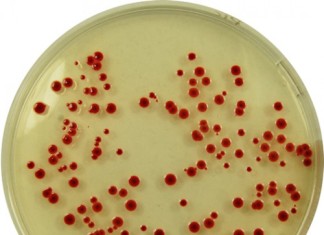

Investigadores mejoran control de la diabetes
Una nueva forma de supervisión del control de la glucemia en la diabetes es un paso más hacia el mercado gracias a una colaboración...
Descubierto en la leche materna de una proteína capaz de neutralizar...
Nueva resultado puede explicar por qué los bebés nacidos de madres VIH positivas no adquieren mas el virus del SIDA a través de la...
Alpecia: Crecimiento del cabello con las propias células del paciente
Investigadores del Centro Médico de la Universidad de Columbia (CUMC), en Nueva York, Estados Unidos, han ideado un método de restauración del cabello que...
Las lentes de contacto cosméticas plantean peligros
Uso de lentes de contacto cosméticas puede parecer una buena manera de complementar un buen disfraz de Halloween, pero pueden causar lesiones oculares graves,...
¿Por qué el estómago hace ruidos?
Cuando la gente escucha el estómago a hacer ruido, la mayor parte de lo que escuchan es gas y la motilidad intestinal, el movimiento...
Investigador desarrolla medicamento que ataca el VIH antes de que se...
Treinta y cuatro millones de personas viven con el virus de la inmunodeficiencia humana, o VIH, en todo el mundo y cada año unos...
Kérastase Densifique contra la alopecia, funciona?
Las primeras marcas de cosmética capilar no hacen más que renovar sus fórmulas o inventar otras totalmente innovadoras, como es el caso del nuevo...
Estudio revela que el cerebro «saca la basura» mientras dormimos
En los resultados que le dan un nuevo significado al viejo adagio de que una buena noche de sueño despeja la mente, un nuevo...
Los psicólogos señalan nuevos conocimientos sobre el cerebro humano, la conciencia
Psicólogos UCLA han utilizado técnicas de imágenes cerebrales para estudiar lo que sucede en el cerebro humano cuando tenía efecto en la inconsciencia. Su...
Combinación de medicamentos puede ayudar a tratar las infecciones parasitarias
Investigadores de la Universidad de Georgia han descubierto que una combinación de dos medicamentos comúnmente recetados para tratar el colesterol alto y la osteoporosis...
Toxina en el marisco se propaga fuera de los EE.UU., dice...
Una enfermedad que causan las bacterias que se encuentran en los mariscos, anteriormente limitados hasta el Pacífico Noroeste de los Estados Unidos, está presentando...
En Brasil se combate la flatulencia con ajo
Una empresa brasileña anunció el miércoles que se lanza al mercado una cápsula de ajo diseñado para hacer frente a la flatulencia.
Una empresa brasileña...